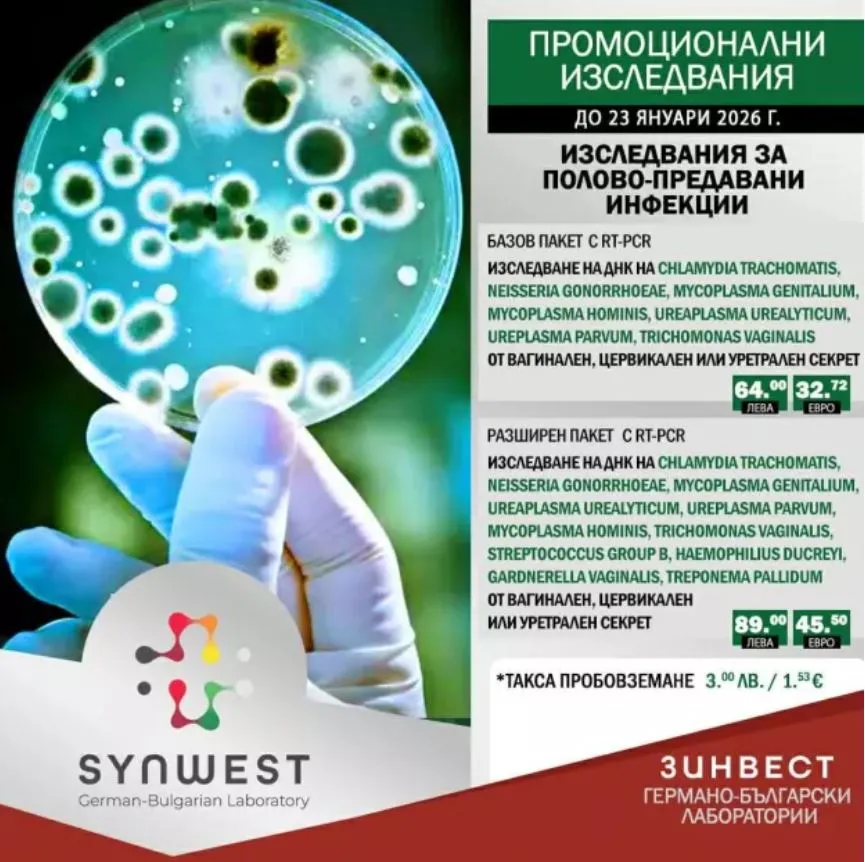
Промоционални изследвания

Панелните PCR изследвания се утвърждават като съвременен и изключително ефективен метод за диагностика на редица инфекциозни заболявания. Те дават възможност за едновременно откриване на множество патогени за кратко време и подпомагат навременното и адекватно лечение. Това обясняват имунологът и микробиолог проф. д-р Мариана Мурджева и вирусологът д-р Хубавина Дженева, част от екипа на Германо-българска лаборатория „Зинвест“ – Пловдив.
„PCR тестовете, предназначени да изследват при инфекции на дихателната система няколко патогена едновременно, се отличават с голяма бързина – резултатите могат да бъдат готови до час-два. Друго важно тяхно предимство е възможността да изследват не само бактерии, но и вируси в биологичния материал, което при класическата микробиологична диагностика е ограничено“, посочва проф. Мурджева.
Разширеният респираторен панел може да определя едновременно около 30 патогена. Той включва детекция на вируси като грипни, парагрипни и различни коронавируси, метапневмовируси, адено-, рино/ентеро-, бока- и пареховируси. Също бактерии като стафилококус ауреус, хемофил, пневмокок, мораксела катаралис, коклюшен и паракоклюшен бактерии, хламидофила пневмоние, клебсиела пневмоние, легионела пневмофила, микоплазма пневмоние. Както и протозои (първаци) като пневмоцистис жировеции, обикновено свързан с инфекции при имунокомпрометирани хора.
„Важно е при дихателни инфекции като фарингит, бронхит или пневмония да се извърши едновременно изследване на тези патогени, защото симптомите могат да бъдат сходни и само по тях да не се разпознае причинителят на инфекцията. А точната диагноза, установена бързо с този метод, е път и към коректното лечение“, обяснява проф. Мурджева.
Тя подчертава, че респираторният PCR панел е особено подходящ при деца, възрастни с хронични дихателни заболявания и имунокомпрометирани пациенти. „При тези групи протичането на инфекцията обикновено е по-тежко, а оздравяването – по-бавно. Навременната микробиологична диагноза осигурява бърз старт на терапията и намалява риска от усложнения“, допълва експертът.
Д-р Хубавина Дженева акцентира върху ролята на PCR тестовете при полово предавани инфекции (ППИ). „Изборът между базов и разширен панел се прави според степента на риска при пациента, целта на изследването и наличието на симптоми. Базовият панел покрива най-често срещаните ППИ, като Chlamydia trachomatis и Neisseria gonorrhoeae, докато разширеният включва по-широк спектър патогенни причинители, включително Mycoplasma genitalium и Trichomonas vaginalis“, обяснява тя.
Специалистът подчертава, че панелните PCR тестове са препоръчителни при пациенти с множество партньори и секс без предпазни средства, необходимост от изследване на разнородни причинители, както и при дългосрочни оплаквания или хронично-рецидивиращи проблеми. Те са изключително важни и при „тихо протичащи“ инфекции, често без видими симптоми.
„Навременното откриване позволява лечение още в ранния стадий, намалява риска от хронични възпаления, безплодие и усложнения при бременност, и ограничава предаването на инфекцията на партньора“, казва д-р Дженева.
PCR тестовете имат голямо значение и при скрининг на пациенти, на които предстоят различни манипулации или оперативни интервенции в тази област. Това се дължи на факта, че PCR (Polymerase Chain Reaction) е метод за директно доказване на генетичен материал на конкретни микроорганизми (вируси, бактерии, паразити). По този начин се доказва активна инфекция, а не само антитела от предишни инфекции в миналото.
Освен това PCR тестовете помагат за избягване на ненужно антибиотично лечение. „Установяването на вирус ограничава ненужната антибиотична употреба, особено ако състоянието на пациента не е тежко. Обратно, доказването на бактерий като причинител на инфекцията, налага прилагането на антимикробни средства, съобразени с вида на патогена“, допълва проф. Мурджева.
Специалистите от „Зинвест“ отбелязват, че чувстителността на PCR тестовете е много висока и достига 100%. PCR панелите се работят ежеседмично (четвъртък или петък). Извършват се върху различни клинични проби – при PCR панела за ППИ се използват вагинални, ендоцервикални, уретрални тампони или урина, а при респираторния PCR панел – назофарингеални секрети и храчки.
Лабораторията предлага и специални промоционални пакети за автоимунни и ревматологични изследвания, витаминен статус, липиден профил, полово предавани и респираторни инфекции, както и изследвания на щитовидната жлеза.
Повече информация може да намерите на интернет страницата на лаборатория „Зинвест“ https://synwest.bg/